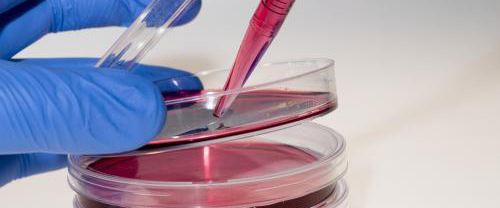

CO2培養箱是實驗室設備的關鍵部件,旨在為生物組織或細胞的培養提供無菌,加濕和pH優化的體外環境。通常有兩種主要類型的培養箱:直接加熱和水套,每種都有明顯的優缺點。為了確定哪種類型的培養箱zui適合您的實驗室需求,應考慮培養箱的位置和要培養的細胞類型,對長期使用進行仔細評估。不同的細胞類型對溫度波動,振動和缺氧等條件具有不同的敏感性,這在決定培養箱之前必須了解。確定培養箱將放置在實驗室中的位置以及細胞理想的居住條件之后,
了解直接加熱與水套培養箱的優缺點顧名思義,水套培養箱在生長室周圍有一個裝滿水的容器,該容器通過通過內壁的傳導來加熱或冷卻內部溫度。外套內的水循環并導致內部溫度和熱量緩沖基本均勻,以防止外部空氣波動。在停電的情況下,這種緩沖液尤其有用,因為水套培養箱的保溫時間是直接加熱裝置的五倍。水套還可以減輕振動,這在處理敏感細胞時可能是很有價值的功能。買家還應考慮到,水套式保溫箱在裝滿后會很沉重,shou次啟動時要達到穩定的工作溫度可能要花費長達24小時的時間。另外,它們的設計不能在足夠高的溫度下進行去污或滅菌的操作。相反,可能需要進行氣體凈化。
直接熱培養箱也通過傳導加熱內腔,但是內壁與加熱線圈(而不是水套)直接接觸。這導致相對快速的溫度變化,而安裝僅需八個小時。此外,加熱線圈可以達到有效凈化所需的溫度,從而使滅菌變得容易。不幸的是,因為加熱線圈在壁內具有離散的接觸點,所以直接熱培養箱在內部腔室內的加熱不太均勻。但是,適當的內部氣流可以減輕這種影響。同樣重要的是要考慮到,隨著周圍空氣溫度的變化,直接熱培養箱的內腔更容易受到溫度波動的影響。如果溫度穩定性至關重要,則水套培養箱可能更合適。
確定培養箱將在實驗室內的位置 -培養箱周圍的環境將在確定您的培養箱需求中扮演重要角色。如果水箱恒溫箱處于熱點且需要冷藏,或者環境溫度經常變化,則可能是zui佳選擇。與直接熱培養箱的盤管相比,水對外部溫度變化的抵抗力更大。水還可以zui大程度地減少培養箱內的振動,如果將培養箱放置在其他劇烈振動的設備(例如離心機)附近,則可能是必要的。購買前確定培養箱的位置將有助于您確定zui合適的培養箱。
評估培養箱的濕度控制-保持培養箱內理想的濕度至關重要,因為它可以防止細胞培養物中的水分蒸發。培養基中的水分蒸發會增加鹽,代謝物和氨基酸的濃度,并導致滲透壓升高,從而損害細胞。培養箱的加濕控制對于減少蒸發非常重要,但是室內的氣流數量和類型也會極大地影響蒸發速率。一些制造商已經引入了降低氣流速度的系統,該系統可zui大程度地減少蒸發以避免干燥細胞培養物。比較培養箱時,要尋找內室中隨時間變化的空氣交換數量。
確定是否需要進行低氧控制并確定氣體傳感器的精度-在培養箱內保持健康的CO2水平非常重要,因為CO2與細胞培養基的緩沖系統相互作用以確定培養基的pH。盡管許多培養箱都使用更傳統的熱導率(TC)傳感器,但新型紅外(IR)傳感器通常更有效,因為它對培養箱的濕度和溫度不那么敏感。O 2的含量也會對某些培養物的生長產生巨大影響,例如干細胞或原代組織。低氧環境更類似于生物體內的狀況。帶O 2控件的培養箱使用氮氣有效降低O的濃度2在生長室內。評估實驗室長期使用培養箱的氣體控制需求至關重要。
考慮進行持續污染控制的選項—只需打開門即可將污染物引入培養箱。在培養室內保持正壓的培養箱可zui大程度地減少流入培養室內的氣流,并可以防止空氣中的污染物進入。然后,內部空氣通常流經HEPA過濾器,以提供額外的滅菌層。如果鼓風機電動機停止運轉并且失去靜壓,導致過濾器中的污染物自由落在培養物中,則生長室內的HEPA過濾器可能會引起問題。外部安裝的HEPA過濾器可使污染物遠離細胞,并且易于維護。選擇培養箱時,值得仔細研究污染控制,因為培養物的無菌性是細胞培養的重中之重。